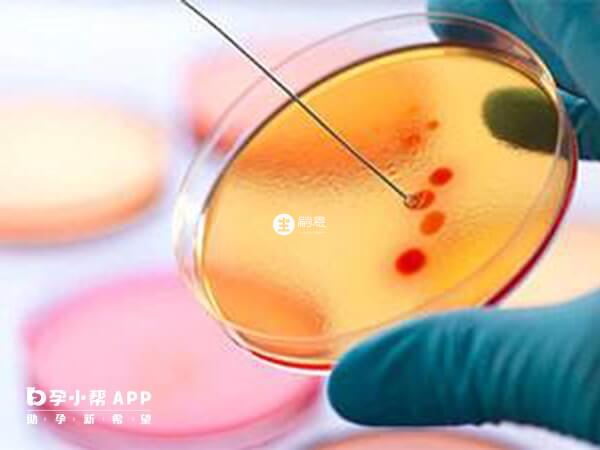

泰国生男孩的试管医院有哪些?这3所成功率都很不错

摘要
结婚3年不孕,月经有时不正常有时正常,去医院检查发现是卵巢早衰,老公有轻微的弱精症,我两就有想做试管的打算,因为听说可以选择胎儿性别,我们都想要生个男孩,但是国内不允许,泰国那边有很多医院听说都可以生男孩,请问具体有哪些呢?泰国试管婴儿政策是非常宽松的,所以大部分泰国试管医院都是可以生男孩的,例如BNH医院、碧雅威医院、杰特宁医院等等。这些医院都是当地知名的大型试管医院,他们的三代技术都非常的成熟,所以生男孩基本上是没问题的,但也不能保证100%就是男孩,毕竟有的患者可能没有含y染色体的胚胎,那么也就只能做试管生女孩。
泰国试管婴儿医院
泰国试管婴儿技术仅次于美国,其三代试管婴儿技术发展的非常成熟,大部分当地医院都可以做试管婴儿,下面就为大家介绍几家比较靠谱的:
- 1. BNH医院:拥有110多年历史的贵族医院,生殖中心的医疗团队经验丰富,生男孩不是梦;
- 2. 碧雅威医院:拥有泰国皇家赞誉的一级医生团队,采用最先进前沿的医学技术;
- 3. 杰特宁医院:在实验室方面,其拥有遗传学实验室和精液实验室,能提高试管生男孩概率。
